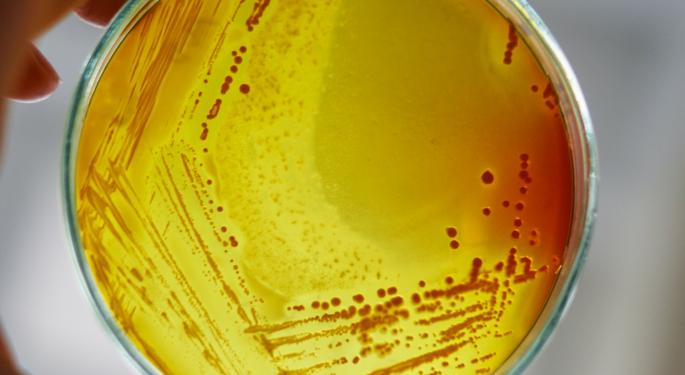

Meet PsyBio, A Company Producing Psilocybin From Genetically-Modified Bacteria
As psychedelics draw closer to legalization, companies in the industry have yet to figure out the most efficient and cost-effective way of producing psilocybin and other molecules on a commercial scale.
To date, the industry has not reached a consensus as to the most effective production method to be used, once demand moves beyond clinical trials.
PsyBio Therapeutics (TSXV: PSYB), a biotech company that uses genetically modified bacteria to biosynthesize psychedelic molecules, might have the answer to one of the industry’s most overlooked conundrums.
Making Psilocybin From Bacteria
PsyBio is a company that was structured around newly discovered technology, especially after its CEO met a certain scientist in Ohio.
Dr. Andrew Jones, a researcher at Miami University in Ohio, discovered a pathway in 2017 for the production of psilocybin in E. Coli, a common species of bacteria.
Jones’ 2019 paper, “In vivo production of psilocybin in E. coli,” noted that developing a psilocybin production platform in microbes could lead to rapid advances toward the production of psilocybin for use in ongoing clinical trials.
“I published this paper knowing that it was going to make an impact,” Jones told Benzinga. “Anytime you make a psychedelic drug in a bacteria, it's a good day.”
However, the scientist did not expect the avalanche of attention his discovery attracted.
“I think for two months after, I was talking to reporters every single day.”
Enter PsyBio
In addition to the media, the discovery caught the eye of a wide range of companies, from small biotechs to venture capital funds. One of those companies was PsyBio whose CEO, Evan Levine, was looking for innovative technology around which to structure his new company.
“Actually, we built PsyBio Therapeutics around Miami University and Dr. Jones’ technology,” Levine told Benzinga. “The company acquired the global exclusive rights to Andrew's platform technology that can biosynthesize a multitude of these tryptamines from genetically modified bacteria.”
Levine has an extensive background in investment banking and portfolio management as well as a seven-year track record as owner and operator of a biotech company called Adventrx Pharmaceuticals Inc.
Jones and Levine hit it off immediately.
“[We] kind of jived in our vision for this industry and what we saw as a future for psychedelic medicine,” said Jones who now chairs PsyBio’s Scientific Advisory Board.
A Pure-Play Psychedelics Biotech
As a result of the partnership, PsyBio became the main financier of Jones’ research. In late April 2021, they reached an agreement to expand the university’s research program with a $1.5 million investment, in addition to a previous $1 million.
The funding enabled Jones to expand his discovery into the development of other tryptamines with potential therapeutic effects.
Secondary tryptamines found in Psilocybe mushrooms, such as norbaeocystin, could produce a synergistic effect when combined together with psilocybin.
Now, in combination with Miami University’s McMurray Lab, researchers are taking their studies into animal models that can shed light on the possible therapeutic benefits of these and other novel compounds, in different combinations.
“We can screen some of my compounds and see which ones have potential therapeutic benefits. That tells me where to focus my genetic optimization efforts, where I'm manipulating the bacteria to enable them to create more of this product,” Jones explained.
Levine’s PsyBio will be working closely with Jones as he and his colleagues move forward.
"We'd like to be looked at as a pure-play biotechnology company," Levine said, adding that PsyBio will not be going into data analytics, psychedelics clinics or other services ancillary to drug research and development.
PsyBio, Levine said, plans to continue filing patents on its discoveries and intends to present Investigational New Drug applications with the FDA by the end of this year, eventually leading clinical trials with its own formulations.
Will Biosynthesis Win The Psilocybin Production Race?
There are multiple methods for producing psilocybin. The most obvious one is extracting it from mushrooms of the Psilocybe genus, which have been producing psilocybin naturally for millions of years.
“I don't see extraction from mushrooms being a future. Mushroom production is really difficult to scale, and it's very inconsistent in the amount of psilocybin you get in the mushrooms,” Jones said. “You also have to worry about degradation. I don't see that as a viable direction, although it is a direction some people are taking.”
The most established technology for pharmaceutical grade psilocybin involves deriving it from a chemical reaction. Synthetic psilocybin produced in this way is the main product being tested in clinical trials today, including those carried out by the Usona Institute and Compass Pathways (NASDAQ: CMPS).
“The problem there is it's incredibly expensive,” Jones said.
“The chemistry that happens in psilocybin, those are things that biology is really good at. Biology has evolved to be able to do those chemistries. So they're really good at their evolved systems to be able to facilitate that kind of catalysis. And that's something that's really hard to mimic in synthetic chemistry.”
Jones added that synthetic chemistry also struggles to produce high yields of modified versions of psilocybin. Typical pharmaceutical drugs are produced at very low yields and generally cost a lot.
“But this happens to be one of the molecules that has evolved for biology to make. It's a natural product. It's not a derived natural product. So there are enzymes that have already been developed for this,” Jones concluded.
Photo by Katarzyna Modrzejewska from Pexels
© 2025 Benzinga.com. Benzinga does not provide investment advice. All rights reserved.
Posted-In: Dr. Andrew Jones Evan Levine Psilocybin PsyBio TherapeuticsCannabis Psychedelics Small Cap Markets Best of Benzinga